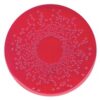

Boc-D-Phe-OH Novabiochem® 25g Merck
0 ₫
Boc-D-Phe-OH sản xuất bởi hãng Merck Đức, code: 8530940025, tồn tại dưới dạng rắn, màu trắng đến vàng nhạt đến be. Được dùng trong nghiên cứu proteomics. Được sử dụng rộng rãi trong phòng thí nghiệm, viện nghiên cứu…Quy cách đóng gói: chai nhựa 25g.
| Tên sản phẩm: | Boc-D-Phe-OH 25g Merck |
| Công thức hóa học: | C₁₄H₁₉NO₄ |
| Code: | 8530940025 |
| Số CAS: | 18942-49-9 |
| Hàm lượng: | ≥ 99.5 % |
| Hãng – Xuất xứ: | Merck – Đức |
| Ứng dụng: | – Được dùng trong nghiên cứu proteomics, sử dụng rộng rãi trong phòng thí nghiệm, viện nghiên cứu… |
| Tính chất: |
– Hình thể: dạng rắn – Màu: trắng đến vàng đến be – Khối lượng mol:265.31 g/mol |
| Bảo quản: | Dưới +30°C |
| Quy cách: | Chai nhựa 25g |
Sản phẩm tham khảo:
| Code | Quy cách |
| 8530940005 | Chai thủy tinh 5g |
| 8530940025 | Chai nhựa 25g |
| 8530940100 | Chai nhựa 100g |
Hãy là người đầu tiên nhận xét “Boc-D-Phe-OH Novabiochem® 25g Merck” Hủy
Sản phẩm tương tự
Hóa chất thí nghiệm
0 ₫
Hóa chất thí nghiệm
0 ₫
Hóa chất thí nghiệm
0 ₫
Hóa chất thí nghiệm
CAL Check™ Chuẩn Amoni Thang Cao, 0.0 và 25.0 mg/L HI96733-11 Hanna
0 ₫
Hóa chất thí nghiệm
Cal Check chuẩn Clo dư và Clo tổng, 0.00 và 1.00 mg/l HI93414-11 Hanna
0 ₫
Hóa chất thí nghiệm
0 ₫
Hóa chất thí nghiệm
0 ₫

Đánh giá
Chưa có đánh giá nào.